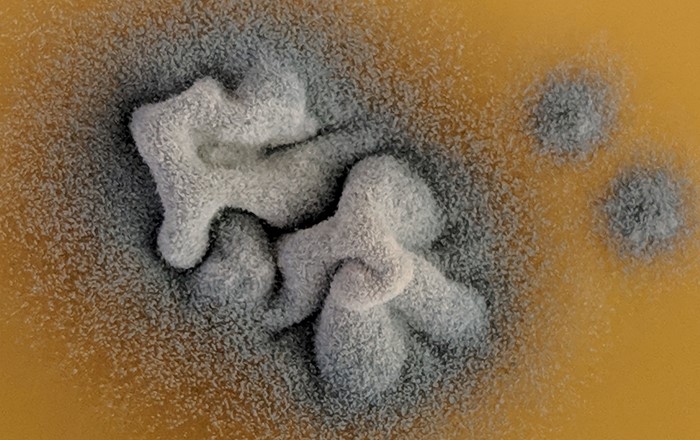

These articles are now archived and will no longer be updated.
-
December 28, 2020Faster, greener way of producing carbon spheres could improve carbon capture technology
A fast, green and one-step method for producing porous carbon spheres, which are a vital component for carbon capture technology and for new ways of storing renewable energy, has been developed by Swansea University researchers.
-
December 22, 2020Covid-19: Medical School and Wuhan partners share innovations with British Ambassador in China
Swansea University’s Medical School has strengthened its unique connection with Wuhan, by joining an online conference of health professionals, also attended by the British Ambassador in China, Caroline Wilson CMG, which has helped to shine a light on healthcare and innovation and Covid-19.
-
December 21, 2020Funding boost for research collaboration studying provision of eye care in the community
A new project set up to study the best way to care for patients with long-standing eye conditions in the community has secured a major research grant.
-
December 18, 2020New international research examines way of fighting back against Covid-19
Researchers at Swansea University Medical School are helping to drive forward understanding of the virus that causes Covid-19 and how it can be tackled.
-
December 18, 2020Medical School course records triple exam success
Swansea University’s physician associate course is celebrating a remarkable hat trick – its students recorded a 100 per cent pass rate in the September PA National Exams for the third year running.
-
December 18, 2020Fire-resistant tropical forest at brink of disappearance in Indonesian regions due to human modification
A new study led by researchers in the Geography Department at Swansea University reveals the extreme scale of loss and fragmentation of tropical forests, which once covered much of the Indonesian islands of Sumatra and Kalimantan.
-
December 16, 2020Europe’s rivers are broken, but there is a fix
A new study published in Nature reveals the true extent of river fragmentation and offers some solutions.
-
December 15, 2020Double delight for Tennessee after master’s distinction
A Swansea University student and world kickboxing champion is finishing 2020 on a high after graduating in her master’s.
-
December 13, 2020University’s Money@CampusLife awarded Stand Alone Pledge Award 2020
Swansea University’s Money@CampusLife team have been awarded a Stand Alone Pledge award for their role in helping estranged students during Covid-19.
-
December 11, 2020New study shows how microalgae could be crucial to circular economy
New Swansea University research has revealed microalgae could play a crucial role in not only successfully reusing food and farm waste on an industrial scale but also creating thousands of jobs.
-
December 11, 2020Book about child Holocaust survivors makes Daily Telegraph’s book of the year list
A Swansea University academic’s latest book, about child survivors of the Holocaust, has been included in the Daily Telegraph’s list of the best history books of 2020.
-
December 10, 2020Designing safer buildings - self-powered wireless sensing systems to detect cracks and damage
Researchers at Swansea University are developing an innovative approach to the design of smart buildings. A new environmentally sustainable, safer and cost-efficient model, designed at the Institute for Innovative Materials, Processing and Numerical Technologies (IMPACT), will offer an improved system for energy supply distribution to sensors in smart structures.
-
December 10, 2020SUNRISE project wins Times Higher Education award
Swansea University in collaboration with international and UK institutions has lifted the International Collaboration of the Year trophy at the 16th annual Times Higher Education Awards.
-
December 9, 2020Pregnant women who stop asthma medication at risk of preterm birth
A new study from Swansea University suggests that women who stop taking their asthma medication during pregnancy are at risk of giving birth prematurely and are less likely to breastfeed their babies.
-
December 8, 2020£4m research funding boost for Welsh manufacturing sector
Manufacturing businesses across Wales can remain at the forefront of innovation, thanks to £4 million of EU funding announced by the Welsh Government.
-
December 8, 2020Judges announced for the Swansea University Dylan Thomas Prize
The judges for the 2021 Swansea University Dylan Thomas Prize have been announced today (8 December).
-
December 4, 2020Community butterfly project set to give nature a helping hand
Swansea University bioscientists are helping a community create a butterfly and wildlife garden in the heart of a Swansea village.
-
December 4, 2020Smarter, greener steelmaking: three new studies to be funded by Swansea-based research programme
Three research projects that could help the steel industry become smarter and greener have been given the go-ahead as part of a national steel research programme led by Swansea University.
-
December 4, 2020New funding for research on COVID-19 and cardiovascular disease
Swansea University has received £125k of funding from Health Data Research UK (HDR UK) to study the impact of the direct and indirect effects of COVID-19 on cardiovascular disease (CVD).
-
December 3, 2020Researcher to deliver keynote address at unique virtual summit
Swansea University researcher Dr Lewis Francis will share his work with a global audience at an international online conference next week.
-
December 2, 2020Research to improve Welsh athletes’ performance gets four-year funding boost
A Wales-wide research project that helps enhance the performance of Welsh athletes will be able to continue its work thanks to a £440,000 grant from Sport Wales.
-
December 1, 2020Study reveals new findings on nature’s UV sunscreens
Swansea University research has provided a new insight into the behaviour of nature’s own UV sunscreens when they are exposed to other parts of the light spectrum.
-
November 30, 2020Swansea University relaunches prestigious Rhys Davies Short Story Competition
Swansea University’s Cultural Institute is relaunching the distinguished national Rhys Davies Short Story Competition for writers from, or living in, Wales.
-
November 27, 2020University cancer research progress leads to partners’ funding boost
A Swansea University project’s ground-breaking work to improve diagnosis and treatment of ovarian cancer has helped it secure more than £3 million of investment from industrial partners.
-
November 24, 2020Turning waste plastic into carbon nanotubes to transmit electricity
The Welsh government is backing a cutting-edge science project at Swansea University that changes waste plastics into highly valuable compounds for the energy industries.
-
November 24, 2020New engineering partnership to develop digital marketplace to improve manufacturing supply chain
A research team, led by Swansea University College of Engineering, are developing a pilot online marketplace designed to optimise manufacturing supply chain networks and create a new industry-wide business model.
-
November 19, 2020University partnership ready to help new businesses make the right connections
A new collaboration is set to give student entrepreneurs a valuable networking boost as they launch their business ideas.
-
November 19, 2020Older, poorer people at greater risk from adverse drug reactions
A review by Swansea University academics has found that older, poorer people who are socially distanced from their doctors or pharmacists, suffer more adverse drug reactions (ADRs) than the general population and that systematic monitoring is needed to protect these patients suffering from reactions which could result in over-sedation, falls, or drug-induced Parkinsonism.
-
November 17, 2020New Richard Burton exhibition tells the story of an international star of stage and screen
A brand new exhibition on Richard Burton’s life reveals the man behind the headlines - the husband, father, reader, writer and passionate Welshman.
-
November 12, 2020Sunlight could turn COVID waste into clean fuel – funding for new Swansea-led project
Sunlight could be used to convert hazardous medical waste into clean hydrogen fuel, using a new technique being developed by a joint Wales/India team led by Swansea University researchers. The project has just been awarded £47,000 of funding by the Welsh Government.
-
November 11, 2020New survey reveals toll Covid-19 is taking on mental health in Wales
Wales faces a wave of mental health problems in the wake of Covid-19, with younger adults, women and people from deprived areas suffering the most.
-
November 5, 2020New funding making a difference to life-saving research projects
Four Swansea University projects aimed at making a life-saving difference to patients’ lives have taken a major step forward.
-
November 5, 2020Scientists develop method to detect charge traps in organic semiconductors
Scientists at Swansea University have developed a very sensitive method to detect the tiny signatures of so called ‘charge traps’ in organic semiconductors.
-
November 5, 2020Warmth not waste: new research will look at re-using waste heat from industry
A new project involving Swansea University researchers and Tata Steel will investigate the potential for recovering waste heat from industry so it can be re-used.
-
November 4, 2020Swansea University outreach project keeps children learning during lockdown
A Swansea University outreach project has helped deliver hundreds of science workbooks to children studying at home during Wales’ fire-break lockdown.
-
November 3, 2020University Navy Plaques mark the spots where memories were made
Meeting a life partner, forging friendships and enjoying a long happy career are just some of the life-changing experiences now commemorated at Swansea University.
-
November 3, 2020Swansea student nurse named best in Britain
When it comes to helping patients prepare themselves for surgery, Rea Pugh-Davies is arguably one of the best around.
-
November 3, 2020Designing low carbon buildings: Swansea team’s know-how gathered in new toolkit for others to use
The team that designed and built two low carbon buildings at Swansea University, which generate their own energy, is publishing a toolkit of the design principles that they used. The aim is to encourage others to construct these “Active Buildings” as it would drastically cut the UK’s carbon footprint; currently 40% of our emissions come from heating and powering our buildings.
-
November 2, 2020New study examines how Covid-19 safety measures are leading to increased anxiety and avoidance behaviour
A new Swansea University study is being launched to investigate how following Covid-19 safety measures may have the unfortunate effect of making people feel less safe, leading to increased anxiety and people avoiding situations and places they once considered safe.
-
October 30, 2020First study to assess risk of COVID-19 to health of domiciliary care workers in Wales
The first study to establish the risk of COVID-19 to domiciliary care workers across Wales is to launch today.
-
October 29, 2020Award for physicist for work on antimatter
A Swansea University physicist has been awarded a prestigious honour by the Institute of Physics for his leadership over thirty years in the field of antimatter science.
-
October 29, 2020Swansea expert helps shape world’s first agreed guidance for people with diabetes to exercise safely
A Swansea University academic has helped draw up a landmark agreement amongst international experts, setting out the world’s first standard guidance on how people with diabetes can use modern glucose monitoring devices to help them exercise safely.
-
October 28, 2020Swansea nursing student scoops prestigious Most Inspirational Student of the Year award
Matt Townsend, an Adult Nursing student from Swansea University, has won the Most Inspirational Student of the Year award in this year’s Student Nursing Times Awards.
-
October 27, 2020Academics call for NHS gambling treatment clinics in Wales
Swansea University academics have called for NHS gambling disorder treatment clinics to be established in Wales, as a letter published in The Lancet reveals the serious impact of problem gambling in Wales, particularly amongst younger people.
-
October 27, 2020Gut hormone blocks brain cell formation and is linked to Parkinson’s dementia, Swansea research reveals
A gut hormone, ghrelin, is a key regulator of new nerve cells in the adult brain, a Swansea-led research team has discovered. It could help pave the way for new drugs to treat dementia in patients with Parkinson’s Disease.
-
October 27, 2020International collaboration will lead to online archive of Dylan Thomas’ work
A digital collection of manuscripts and photographs related to the Welsh poet and writer Dylan Thomas will soon be available online thanks to an international collaboration.
-
October 26, 2020University’s double success at diabetes awards
A Swansea University honorary senior tutor and a master’s student have been honoured for their dedication to diabetes care at a major UK healthcare awards.
-
October 26, 2020New animation helps lymphoedema patients recognise symptoms
A new animated video has been developed by Swansea University to raise awareness of lymphoedema and help patients understand more about how their condition will be treated.
-
October 23, 2020SUNRISE project shortlisted for Times Higher Education award
SUNRISE has been shortlisted for ‘International Collaboration of the Year’ in the 16th annual Times Higher Education (THE) Awards.
-
October 23, 2020Professor’s new role helping to promote nanomedicine across the UK
Swansea University Medical School’s Professor Steve Conlan has taken up a key role helping to highlight UK nanomedicine research.
-
October 20, 2020Boost for Wales’s lead in green solar technology thanks to EU funding
Wales can remain at the forefront of next generation solar energy technology, for applications such as remote sensors and electric vehicles, thanks to £2.5 million of EU funding announced by the Welsh Government, to continue a Swansea-led research programme.
-
October 19, 2020Power to the People: Swansea expert marks prestigious award with lecture on how coated steel can harness solar energy
Coated steel can harness solar energy and cut carbon emissions, a Swansea expert will explain in a public online lecture, which is being held to mark him being awarded the prestigious Bessemer Gold Medal by the Institute of Materials, Minerals and Mining.
-
October 16, 2020Researcher receives Royal Society of Biology Outreach and Engagement Award
Swansea University postdoc researcher Dr Claire Price has been recognised for her work to make science more accessible to the community in her home town.
-
October 15, 2020Lockdown mental health problems amongst family carers up to 10 times higher – new study
Family carers for children and adults with intellectual disabilities have reported rates of mental health problems under lockdown that are up to 10 times higher than parents without those responsibilities, a new study has found.
-
October 15, 2020Swansea University judged one of country’s best green spaces
Swansea University has once again been named among the winners of this year’s Green Flag Awards – the international mark of a quality park or green space.
-
October 8, 2020New module allows engineering students to work remotely with Texas team
A group of engineering students have taken up a module run by Texas A&M University, which involves working remotely with fellow engineers overseas, thanks to a new initiative by the College of Engineering, which is founded on Swansea University’s Texas links.
-
October 8, 2020Student Matt says Covid-19 taught him what it really means to be a nurse
When Swansea University nursing student Matt Townsend was given the opportunity to join the NHS frontline at the height of coronavirus crisis, he knew just what he had to do.
-
October 7, 2020Welsh Government funding at ESRI for next generation PPE
Welsh Government have announced funding for the Energy Safety Research Institute (ESRI) at Swansea University to develop a unique approach to next generation Personal Protective Equipment (PPE) in the fight against viruses.
-
October 5, 2020Wales Women prepare for Scotland clash at Swansea University
Wales Women are using Swansea University’s sports facilities as they prepare for their Six Nations clash against Scotland.
-
October 5, 2020Being Human Festival returns for seventh year
Swansea University’s Cultural Institute has been chosen as one of four hubs for Being Human 2020, the UK’s only national festival of the humanities.
-
October 2, 2020Award to fund display on cultural diversity and racism in the ancient world
An expert in ancient history and Swansea’s Egypt Centre have been jointly awarded £1100 to develop a new display on Egypt and its neighbours, which will be used for the Centre’s education programme on issues such as identity, racism and xenophobia in the ancient world.
-
October 1, 2020Study shows how pandemic has hit vital breastfeeding support
A new research collaboration led by Swansea University has highlighted a lack of high-quality breastfeeding support for some families during the Covid-19 pandemic.
-
October 1, 2020Swansea University announces star-studded lineup for the 2020 Swansea Science Festival
October will see the return of the Swansea Science Festival, with a host of special guests including Professor Brian Cox, Steve Backshall, Konnie Huq, Iolo Williams and Lyn Evans.
-
September 25, 2020Swansea experts launch new podcast on the US 2020 presidential campaign
Researchers from Swansea University have launched a new podcast series which uses real-time data from political gambling markets to analyse the US 2020 presidential campaign.
-
September 24, 2020University marks double sustainability success
Swansea University’s commitment to sustainability has led to a double achievement.
-
September 24, 2020£3.7m circular economy innovation funding to support south Wales organisations
A new £3.7m project will help public service organisations in south Wales work collaboratively to develop new regional service solutions to existing circular economy challenges.
-
September 23, 2020Help with groundbreaking research to find ways of improving recovery from Covid-19
Researchers exploring a new method to help people recover from Covid-19, using breathing exercises and a hand-held device, are looking for volunteers who have had Covid to help them test it. The work could benefit patients and ease the strain on the NHS.
-
September 22, 2020University gets behind drive to make Wales recycling world champion
Swansea University has literally gone green to hammer home the recycling message.
-
September 18, 2020Citizen scientists show that UK rivers are in pieces
New research led by Swansea University academics and assisted by citizen scientists, has found that 99% of river basins in the UK are fragmented by artificial barriers like dams, weirs, and culverts. Urgent action is needed to reconnect rivers, to ensure their long-term health, and the health of the communities around them.
-
September 17, 2020University helps keep 1,100 pupils learning over lockdown
More than a thousand pupils in South Wales were given a helping hand with their studies during lockdown, thanks to a project involving Swansea University.
-
September 15, 2020Participatory approach expands global instream infrastructure inventories
An international team of researchers – including some from Swansea University – have used remotely sensed data available through a Google Earth Engine to identify, map, and validate instream infrastructure such as dams, weirs, and locks across the world.
-
September 11, 2020Protests, strikes and sharing a room with Paul McCartney. . .
Swansea University has seen thousands of students pass through its doors in the past 100 years, but few can have had a more eventful time than Jeffrey Temple.
-
September 11, 2020University develops new Value-Based Health and Care programme
Swansea University has developed a dedicated Value-Based Health and Care (VBHC) programme in conjunction with strategic partner, Sprink Ltd, as part of its Executive Education offer.
-
September 10, 2020University to develop advanced energy storage systems with new £1 million venture
A Swansea University research team from the College of Engineering are to form a new partnership with major global energy solutions provider ENSERV POWER.
-
September 9, 2020Swansea health and medicine students recognised for volunteering in Covid-19 crisis
Around 1000 healthcare and medical students who have volunteered during the Covid-19 pandemic are to receive a voucher for a local business, thanks to a donation of £27,500 by Santander, through Santander Universities.
-
September 8, 2020True size of prehistoric mega-shark finally revealed
A new study led by Swansea University and the University of Bristol has revealed the size of the legendary giant shark Megalodon, including fins that are as large as an adult human.
-
September 7, 2020Swansea University climbs to 24th in the Guardian University Guide
Swansea University has achieved its highest ever rank in any UK league table after rising from 31st to 24th in the Guardian University Guide 2021.
-
September 7, 2020Kier appointed for £30m CISM building project at Bay Campus
A new state-of-the-art facility at Swansea University that will bring together groundbreaking research with technology development in the field of semiconductor science and engineering, is one step closer with the execution of the main build contract with Kier for the Centre for Integrative Semiconductor Materials (CISM) at the Bay Campus
-
September 4, 2020Distance is no hurdle as Chinese students’ language classes continue online
Chinese students, eager to prepare for Swansea University courses, have been continuing their studies - even though their teachers were more than 5,000 miles away.
-
September 4, 2020Back to school safely: pupils in 12 local schools protected by Swansea Uni hand sanitiser
Children returning to lessons at 12 local schools this week are the latest people to be protected by hand sanitiser made at Swansea University, where a solar tech lab has temporarily switched production during the COVID-19 outbreak.
-
September 3, 2020Study focuses on best way to handle 999 calls from Covid-19 patients
A new Swansea University study examining the best way for ambulance services to deal with suspected Covid-19 999 calls has just won major funding support.
-
September 3, 2020Osteopathy services resume at Swansea’s Health and Wellbeing Academy
Swansea University’s Health and Wellbeing Academy (HWA) will begin providing osteopathy services to the general public again from Monday 7 September.
-
September 2, 2020New research unveils environment drivers of ecological complexity in marine intertidal communities
Environmental conditions such as sea surface temperature and the occurrence of cold water upwelling events drive the structure of interaction networks in marine intertidal communities via their effects on species richness, according to new research.
-
September 2, 2020Investment of £20m extends AgorIP project to 2023
The AgorIP Project which has helped the Welsh economy and innovation in west Wales to prosper over the last four years, has been extended to benefit all of Wales, with a total investment of more than £20m.
-
September 2, 2020New report warns of massive decline in freshwater fish populations and threat to livelihoods
The Living Planet Index for Migratory Freshwater Fish, the first comprehensive global report on the status of migratory fish has revealed that there has been a 76% average decline in freshwater fish populations from 1970 to 2016 - including a staggering average decline of 93% in Europe.
-
September 1, 2020Teachers welcome return to school but highlight concerns - survey
As schools reopen, a survey of primary school staff in Wales shows that they support children going back to their classes, for the sake of their education and social development, but that they also have real concerns.
-
August 28, 2020Swansea University announces £230,000 funding boost for student experience
Students at Swansea University are set to benefit from a funding boost dedicated to a programme of events for new and returning students from September 2020 to February 2021.
-
August 26, 2020Microneedle skin patches to administer vaccines
A revolutionary new way to give vaccines through microneedle skin patches is being tested at Swansea University, thanks to £200,000 of EU funding announced by the Welsh Government.
-
August 25, 2020Study shows inbreeding reduces cooperation in banded mongooses
Inbreeding can reduce cooperation in banded mongooses according to a recent study by researchers.
-
August 20, 2020Star author David Walliams backs University’s schools contest
Best-selling children’s author David Walliams has given his support to a children’s competition being held to mark Swansea University’s centenary.
-
August 20, 2020Animal mummies unwrapped: hi-res 3D X-rays reveal secrets of life and death in ancient Egypt
Three mummified animals from ancient Egypt have been digitally unwrapped and dissected by researchers, using high-resolution 3D scans that give unprecedented detail about the animals’ lives – and deaths - over 2000 years ago.
-
August 19, 2020University unveiled as Swansea City’s new front of shirt sponsor
Swansea University is delighted to announce that it will be the new front of shirt sponsor for Swansea City ahead of the forthcoming 2020-21 season.
-
August 14, 2020Researchers capture footage of fluid behaving like a solid
Researchers from the College of Engineering have captured the moments a fluid reacts like a solid through a new method of fluid observation under pressurised conditions.
-
August 14, 2020University experts leading the way on pandemic research
Four Swansea University academics are part of major new research project investigating Covid-19 and what it can teach us about coping with future pandemics.
-
August 14, 2020Discovery charity awarded funding to assist in COVID-19 pandemic
Discovery SVS has been awarded two grants from Welsh Government for its work in alleviating the impact of COVID-19 in Wales and communities in Africa.
-
August 12, 2020Ospreys, Wales and Lions rugby star James Hook to be University attack coach
International rugby star James Hook, who played 81 times for Wales and toured with the 2009 British and Irish Lions in South Africa, has taken up the position of Attack Coach for Swansea University rugby teams.
-
August 12, 2020Project reveals how algae could play crucial role in sustainable food production
A ground-breaking Swansea University project is using microalgae to explore how to reuse waste while increasing food production.
-
August 12, 2020Swansea wins bid to recruit 250 extra engineering students
Swansea University has been successful in its bid to the Department for Education (DfE) to recruit 250 extra engineering students as part of a Government drive to provide over 9,000 additional places at UK universities for courses that will deliver vital services, support the economy and create positive outcomes for students.
-
August 7, 2020University welcomes new Research and Innovation Pro-Vice Chancellor
Swansea University has welcomed a new Pro-Vice Chancellor to its senior management team, with responsibility for the University’s Research and Innovation portfolio.
-
August 7, 2020Four-year delay in getting autism diagnosis, but online tools can cut the wait
Parents concerned that their child may have autism spectrum disorder (ASD) can wait up to four years for a formal diagnosis, but online assessments can help reduce these delays, two new research studies from Swansea University have shown.
-
July 31, 2020Project helping to reduce burn casualties in Nepal
A burn prevention project backed by Swansea University experts has had a dramatic effect on communities in Nepal.
-
July 31, 2020Swansea University’s Academi Hywel Teifi contributes to AmGen programme
The first week of August promised to be a busy one for Tregaron this year, but now that the main festival will not be held there, the Eisteddfod has launched the 2020 AmGen Festival – a project that will give people a taste of the main festival between 30 July and 8 August, all available on S4C, Radio Cymru and the Cymru Fyw website.
-
July 26, 2020£6 million award to drive next-generation solar technology into new applications
A £6 million award will drive next-generation solar technology into new applications.
-
July 24, 2020University innovation team helping to develop high-tech dementia aid
Swansea University innovation experts are helping to refine a high-tech device which is already making a vital difference to people living with dementia and their carers.
-
July 23, 2020University centenary competition invites pupils to look to the future
Swansea University is marking its centenary by asking children to share their vision of how it would look in another 100 years.
-
July 22, 2020New partnership set to examine how algae could be key to safer sunscreens
A Swansea University project exploring how to use algae to create the next generation of sunscreens has now teamed up with an award-winning skincare firm to help develop the idea.
-
July 22, 2020Delight for Julia after 50-year wait to graduate
A retired civil servant is celebrating after graduating from Swansea University - 50 years later than planned.
-
July 20, 2020Sky’s the limit for Swansea students after graduation
Two students are looking forward to their global aviation business soaring even higher after graduating from Swansea University.
-
July 19, 2020The Prince of Wales records message for Swansea University’s centenary
The Prince of Wales has recorded a special video message for Swansea University as it celebrates its centenary on 19 July.
-
July 17, 2020Study shows how traumatic experiences can leave their mark on a person’s eyes
New research by Welsh academics shows that a patient’s pupils can reveal if they have suffered a traumatic experience in the past.
-
July 17, 2020Swansea University to use centenary celebration funds to fight Covid-19
Swansea University, which this year is marking its centenary, is to channel funds that were previously earmarked for celebration events, into fighting Covid-19 and to champion innovation.
-
July 16, 2020Wonders of animal migration: how sea turtles find small, isolated islands
One of Charles Darwin’s long-standing questions on how turtles find their way to islands has been answered thanks to a pioneering study by scientists.
-
July 15, 2020Swansea University ranked 6th in the UK for student satisfaction
Swansea University has been ranked sixth for overall student satisfaction in the 2020 National Student Survey (NSS).
-
July 14, 2020Experts’ high-flying study puts soaring birds in spotlight
New research has revealed when it comes to flying the largest of birds don’t rely on flapping to move around. Instead they make use of air currents to keep them airborne for hours at a time.
-
July 9, 2020Swansea student’s family inspire award-winning idea for disability aid
A Swansea University student’s personal experience was the inspiration for his winning entry in a nationwide hunt for the best new innovation in disability products.
-
July 9, 2020University joins nationwide initiative to help students into higher education
Swansea University has signed up to be part of a new online initiative aimed at supporting students disadvantaged by the coronavirus pandemic to enter higher education.
-
July 9, 2020University lecturer scoops prestigious British Science Association award
A Swansea University lecturer has won the prestigious Jacob Bronowski Award for Science and the Arts from the British Science Association.
-
July 6, 2020Students step up to offer support in time of crisis
Two Swansea University students have been working to support the emergency services during the Covid-19 pandemic.
-
July 3, 2020Swansea University shortlisted in Guardian University Awards 2020
Swansea University has been shortlisted for Best Student Experience in the Guardian University Awards 2020.
-
July 3, 2020Welsh super database and technology platform play major role in new international Covid-19 research collaboration
The Secure Anonymised Information Linkage (SAIL) Databank, funded by Health and Care Research Wales, has been selected to play a key role in an international collaboration to accelerate Covid-19 research.
-
July 3, 2020Helicopter or cartwheel? How molecules rotate determines what happens when they collide with surfaces
What happens when a molecule collides with a surface? Researchers at Swansea University have shown that the orientation of the molecule as it moves – whether it is spinning like a helicopter blade or rolling like a cartwheel - is important in determining what happens in the collision.
-
July 2, 2020Couple share happy memories of University dubbed Butlin's-by-the-Sea
Sandra and Bob Cuthill will definitely be among those raising a glass to Swansea University when it marks its centenary this month.
-
July 2, 2020£6m EU investment in SPECIFIC Innovation & Knowledge Centre recognises project’s success
In 2011, SPECIFIC was one of six UK Innovation and Knowledge Centres (IKCs) created by the UK Government.
-
July 2, 2020Swansea academics join call for statutory levy on gambling firms
Academics warn current system gives industry too much influence on how money is spent.
-
July 1, 2020New doctors praised at University’s first-ever virtual graduation celebration
More than 150 former students reunited to celebrate their time at Swansea University Medical School with a unique virtual graduation celebration.
-
July 1, 2020Swansea University student receives prestigious Diana Award in recognition of voluntary work
Isabel Francis, a law student at Swansea University, has been recognised with the highest accolade a young person aged between 9 and 25 can achieve for their social action or humanitarian efforts – The Diana Award.
-
June 30, 2020Face shields designed by University team get CE mark for safety for NHS to use
Face shields to protect NHS staff, designed and 3D printed by a Swansea University team, have been awarded the CE safety mark, which means they can now be manufactured at larger scale for hospitals.
-
June 30, 2020University’s popular bike share scheme re-opens
Cyclists in Swansea will be back in the saddle from July 1 following the decision to re-open the University’s popular bike share scheme.
-
June 29, 2020Call to reconnect Europe’s rivers as one million barriers found
New research has found that Europe’s rivers are the most fragmented in the world, with up to one million barriers blocking their flow, and urgent action to reconnect them is now vital to ensure the long-term health of these rivers and their surrounding habitats.
-
June 26, 2020Project to help health staff using PPE facemasks communicate scoops innovation award
Swansea University’s Healthcare Technology Centre has played a key role in developing an award-winning communication aid for frontline health staff forced to wear face masks during the pandemic.
-
June 26, 2020CSconnected project receives UK government funding through UKRI
The UK Government has announced the first wave of funding through UK Research and Innovation’s flagship Strength in Places Fund in which a major £43.74M project with South Wales’ compound semiconductor cluster has been approved and will be supported by £25.44M funding from Strength in Places.
-
June 25, 2020Shaped by Steel - Swansea's first Twitter conference is open to all
‘Shaped by Steel’ is the first ever ‘Twitter’ conference to be hosted by Swansea University. With more traditional ‘face-to-face’ conferences cancelled due to the COVID-19 pandemic, the History Department’s ‘Social Worlds of Steel’ research project team is taking to Twitter as an alternative way to share research and heritage practice to a different audience – the Twittersphere.
-
June 25, 2020Researchers uncover new environmentally-friendly approach to water treatment
Researchers from Swansea University have developed a new environmentally friendly method for removing toxic chemicals from water.
-
June 24, 2020Pioneering single process could help safeguard water quality, environment and health
A research team at Swansea University have developed a new method for fast removal and detection of wastewater pollutants that come from everyday pharmaceuticals like paracetamol, ibuprofen and aspirin, which could help minimise their impact on the environment.
-
June 18, 2020Historian’s new book reveals Swansea University’s key role during WW2 and its aftermath
The history of Swansea University comes under the microscope in a new book published to mark the university’s centenary year in 2020.
-
June 18, 2020University professor honoured for exceptional contribution to innovation and science
Swansea University’s Professor Dave Worsley has won a prestigious St David Award for his contribution to Innovation, Science and Technology.
-
June 18, 2020Young people benefit from Swansea University’s community grant during pandemic
Swansea University has awarded a community grant of £250 to homelessness charity Llamau.
-
June 17, 2020Swansea student’s role helping to ensure hospital staff stay protected
A Swansea University student is playing a key role in managing supplies of PPE at one of the hospitals hit hardest by the pandemic.
-
June 16, 2020Swansea University researchers take up cancer fundraising baton
Cancer researchers from Swansea University have set themselves the epic challenge of cycling more than 4,500km this June to raise money for Tenovus Cancer Care and Maggies Cancer Centres.
-
June 16, 2020Academi Hywel Teifi contributes to Tafwyl’s programme of events
The partnership between Swansea University's Academi Hywel Teifi and Tafwyl continues once again this year as the popular festival moves online due to the coronavirus pandemic.
-
June 12, 2020Free English lessons go online to continue during lockdown
Swansea University’s free English language lessons for beginners are still going strong despite lockdown.
-
June 10, 2020Be part of new project to shape mental health and wellbeing support in Wales after Covid-19
Researchers behind a major new study charting how the people of Wales have coped with coronavirus are appealing for volunteers to share their experiences.
-
June 10, 2020Recovering from coronavirus: new ventilator can save lives and create jobs
A team of Swansea doctors and engineers has designed a new ventilator that can be built quickly from local parts and – crucially - used even for patients with severe coronavirus. Until now, ventilator designs could either be one or the other, but not both.
-
June 10, 2020PhD student wins Swansea University 3MT competition final
A Swansea University PhD student has won the Swansea University Three Minute Thesis (3MT) final.
-
June 9, 2020Swansea reaches its highest ever position in the Complete University Guide
Swansea University has been ranked joint 32nd in the 2021 Complete University Guide League Tables – its highest ever position.
-
June 5, 2020Real living wage accreditation for Swansea University
Swansea University has been accredited as a real living wage employer by the Living Wage Foundation (LWF).
-
June 4, 2020Swansea University student crowned UK FameLab champion
Swansea University student Rebecca Ellis has been declared this year’s UK champion of FameLab - the world’s foremost science communication competition.
-
June 1, 2020Discovery: More than 50 years of changing lives
As part of Volunteers’ Week across the UK (1-7 June), we look at the way Discovery continues to help change lives in South Wales and across the globe.
-
May 29, 2020S4 Science: Online science resources keep kids learning during lockdown
Outreach scientists and academics from Swansea University have been hard at work in their kitchens and gardens producing online science workshops, lessons, and science club content to give school students the support and resources they need to continue their science learning from home, during lockdown.
-
May 29, 2020Researchers develop new method to map cholesterol metabolism in brain
A team of researchers led by Swansea University have developed new technology to monitor cholesterol in brain tissue which could uncover its relation to neurodegenerative disease and pave the way for the development of new treatments.
-
May 27, 2020Swansea University announces it will be open and ready to teach at the start of the new academic year
Swansea University has announced its intention to be open and ready to teach online and in person at the beginning of the new academic year in September 2020.
-
May 27, 2020Medical School head appointed to board of local NHS
Professor Keith Lloyd, head of Swansea University’s Medical School, has been appointed Independent Member of the Swansea Bay University Health Board (SBUHB).
-
May 26, 2020Viruses in lobsters: study sheds light on disease and fragile ecosystems
Levels of virus infection in lobsters seem to be related to habitat and other species, new studies of Caribbean marine protected areas have shown.
-
May 22, 2020Imperial Subjects: Wales and South Asia – digital discussion a big success
A digital discussion session on the imperial links between South Asia and Wales brought together more than 150 delegates from all over the globe, attending via Zoom.
-
May 22, 2020Swansea University’s double success reaching FameLab final
Nine of the finest new science voices from across the country, including two from Swansea University, will battle to represent the UK in FameLab – the world’s foremost science communication competition.
-
May 21, 2020Antarctic climate change research with Tasmania gets go-ahead
Research into the effect of climate change in the Antarctic has been boosted by an award of $20 million (£10 million) from the Australian government for work led by the University of Tasmania in partnership with Swansea University glaciologists.
-
May 21, 2020New study examines risks facing frontline medical staff during pandemic
A leading Swansea University clinician is among a group of experts calling for the introduction of a risk assessment for frontline health professionals treating coronavirus patients.
-
May 21, 2020Public torn over COVID-19 contact tracing apps, study shows
A study by researchers at Swansea University and Manchester University suggest that people are torn over whether they will use the COVID-19 contact tracing smartphone app, which is planned for release in the UK later this month.
-
May 21, 2020Medical School appoints two honorary professors in pharmacy
Swansea University Medical School has appointed two key members of staff as it prepares to launch its new pharmacy course.
-
May 21, 2020Swansea academics receive Learned Society of Wales medals
Two academics from Swansea University are among the latest recipients of the Learned Society of Wales’ medals, announced at the Society’s AGM on Wednesday, 20th May.
-
May 20, 2020Swansea University experts deliver Welsh-medium science activities online as part of virtual Eisteddfod
Scientists from Swansea University will launch a series of Welsh-medium online activities for children as part of the alternative, redesigned Urdd National Eisteddfod event to be held online from 25-30 May.
-
May 18, 2020Hillary Clinton praises Swansea University’s response to Covid-19 crisis
Secretary Hillary Clinton has praised Swansea University staff and students for their “critical response” to the Covid-19 pandemic.
-
May 14, 2020Bryan Washington wins £30,000 Swansea University Dylan Thomas Prize
Twenty-seven-year-old American writer Bryan Washington has been named the winner of the £30,000 Swansea University Dylan Thomas Prize for his debut short story collection, LOT.
-
May 14, 2020Care homes and frontline housing teams now using University-made hand sanitiser
Frontline housing workers, homelessness support services and the people they look after, many of whom are vulnerable, are the latest groups to be using hand sanitiser made at Swansea University, where a solar tech lab has temporarily switched to producing 5000 litres a week during the COVID-19 outbreak.
-
May 13, 2020Medical School wins major boost to nanomedicine research
Swansea University Medical School has secured a prestigious funding boost to accelerate the transition from discovery research to development projects in the field of nanomedicine.
-
May 13, 2020£5m funding announced for primary and emergency care research in Wales
The Welsh Government is to invest £4.85m over the next five years on research into primary and emergency care in Wales, which will involve Swansea University.
-
May 8, 2020Professor to deliver keynote address at unique virtual research summit
Swansea University’s Professor Steve Conlan will be the keynote speaker at the world’s first virtual summit on cancer and immunology research.
-
May 7, 2020Innovative online test set to welcome more international students to Swansea University
International students who want to study in Swansea will now be able to sit a crucial English language test online, ensuring their University applications can continue as normal.
-
May 7, 2020Nursing graduate’s pride at being part of NHS
A Swansea University graduate has spoken of her immense pride at being part of the NHS during the Covid-19 pandemic.
-
May 6, 2020University's help for disabled people and their Shared Lives carers during lockdown
Disabled young people and adults will be able to benefit from health and wellbeing advice from Swansea University as they cope with life in lockdown.
-
May 6, 2020Short story launched for young children in South Wales
Freshwater Interdisciplinary Research and Engagement (FIRE) Lab at Swansea University have helped launch a short-animated film for young children in South Wales and beyond.
-
May 6, 2020New study to identify highest risk factors for COVID-19
Scientists from across the UK, including Swansea University, are calling on the public to sign up to a new study which will help identify who is most at risk of contracting COVID-19 and why some people become more ill than others with the disease.
-
May 1, 2020Academics help give pupils a virtual view of University life
Swansea University academics are among the world-leading experts sharing their knowledge to help Welsh sixthformers with their studies during lockdown.
-
May 1, 2020Research into lockdown: do short-term benefits translate into long-term benefits?
New research from Swansea University suggests that short, intensive lockdowns to flatten the COVID-19 epidemic curve could actually cost more lives – and instead the overall case numbers could be minimized by introducing a range of measures over a long period of time.
-
May 1, 2020Nursing students say they are ready to play their part during pandemic
Swansea nursing students say they are proud to be able to face the challenge of joining the NHS during the pandemic.
-
April 23, 2020The show must go on! Swansea student helps keep choir singing during pandemic
They may not be able to rehearse in person but a Swansea University student has found a way for his choir to keep performing during the coronavirus outbreak.
-
May 1, 2020University announces new three-year partnership with Swansea City
Swansea University is delighted to announce a new three-year partnership with Swansea City Football Club until the end of the 2022-23 season.
-
April 30, 2020Waves and tides overshadow human impact on marine life in Swansea Bay
The biggest impacts on the sea life in Swansea Bay come from waves and tides rather than human activity, a wide-ranging new study - encompassing over 170 species of fish and other sea life such as crabs, squid and starfish - has revealed.
-
April 29, 2020University’s link to Wuhan brings experts together in fight against Covid-19
Swansea University has used its unique connection to Wuhan to bring together health experts from across Wales with some of the first medics to tackle coronavirus.
-
April 29, 2020Researchers looking for child participants in online survey on health and wellbeing
Researchers at Swansea University are looking to ask children age 8-11 to take part in an online questionnaire to understand more about their health and wellbeing during the Covid-19 lockdown.
-
April 29, 2020Swansea University academics Honoured by Welsh Academy
Five Swansea University academics are among the new entrants to the Learned Society of Wales’ Fellowship.
-
April 27, 2020Funding for team to test speed clean of ambulances carrying Covid-19 patients
Swansea University has successfully won funding to reduce the time it takes to sanitise ambulances after carrying a suspected Covid-19 positive patient.
-
April 23, 2020University language training beats lockdown by launching online CELTA programme
Swansea University’s English Language Training Services is continuing to run its prestigious Cambridge CELTA programme despite the lockdown.
-
April 22, 2020Experts demand urgent government action to prevent coronavirus suicide risk
Governments need to give ‘urgent consideration’ to their public health response to prevent any possible impact of the coronavirus pandemic on the number of suicides, experts warn.
-
April 21, 2020School of Law’s research centre invited to join global counter-terrorism research network
The Cyber Threats Research Center (CYTREC), based at the Hillary Rodham Clinton School of Law at Swansea University, has been formally invited to join the United Nations Counter-Terrorism Committee Executive Directorate’s (CTED) Global Research Network (GRN).
-
April 20, 2020Swansea University professor becomes Fellow of the Academy of Social Sciences
Swansea University academic Norah Keating is among a group of eminent social scientists who have been honoured by the Academy of Social Sciences.
-
April 17, 2020Extinction of threatened marine megafauna would lead to huge loss in functional diversity
The extinction of threatened marine megafauna species could result in larger than expected losses in functional diversity, according to research led by Swansea University.
-
April 17, 2020Coronavirus lockdown: new study into the effect on physical activity and wellbeing
A team of researchers has launched a new study to examine the effect of the UK Government’s lockdown strategy on the population’s physical activity levels and wellbeing during the Covid-19 pandemic.
-
April 16, 2020COVID-19 social distancing having significant impact on mental health, study shows
A study by researchers at Swansea University and Manchester University shows social distancing and isolation is having a significant impact on people’s mental health and emotional wellbeing.
-
April 16, 2020Trio of Swansea University scientists go from lab bench to backbench
A trio of Swansea University scientists swapped their lab coats for legislation when they spent a week in Westminster at the Houses of Parliament and Whitehall.
-
April 15, 2020University psychologists provide support to isolated patients
Swansea patients whose appointments have had to be cancelled because of coronavirus are getting expert support over the phone instead so they can continue their treatment.
-
April 15, 2020Swansea students develop solution to improve emergency vehicle response times
A team of Swansea University students have developed a solution to improve emergency vehicle response times in a worldwide competition involving over 40 universities.
-
April 14, 2020From solar to sanitiser – Uni team producing 5000 litres a week for NHS
A solar tech lab at Swansea University has temporarily switched to producing 5000 litres of hand sanitiser a week, to help the NHS fight the Covid-19 outbreak.
The sanitiser, which meets the standard set by the World Health Organization, is already in use in the local NHS.
-
April 8, 2020COVID-19 and the 1918-19 ‘Spanish Flu’: differences give us a measure of hope
Dr Michael Bresalier, lecturer in the History of Medicine at Swansea University, has published a historical perspective that highlights important differences between COVID-19 and the 1918-19 influenza pandemic.
-
April 8, 2020Technocamps shortlisted for new Welsh STEM Award
Swansea University’s innovative schools’ outreach programme is in the running for a top award for its work promoting diversity in the world of science education. -
April 7, 2020University maternity expert hosting free online antenatal classes
Mums-to-be whose antenatal classes have had to be cancelled because of the coronavirus are now taking advantage of free online advice from a Swansea University expert.
-
April 7, 2020Student support for disabled people continues through virus crisis
Student volunteers who work with disabled adults are staying in touch with them despite the coronavirus crisis, by offering support over the phone and getting them involved in online activities to help others.
-
April 7, 2020Debut poets dominate the shortlist for the 15th anniversary of the Swansea University Dylan Thomas Prize
Celebrating the Prize’s 15th anniversary, the Swansea University Dylan Thomas Prize recalls its namesake thanks to the dominance of young and experimental poets showcased on its shortlist each of whom are in the running for the £30,000 prize.
-
April 6, 2020Medical students join NHS workforce to battle coronavirus
Final year medical students from Swansea University are joining NHS staff in the fight against Covid-19.
-
April 3, 2020University’s high-tech help to share vital health information
Innovation experts at Swansea University are playing a key role in improving the way hospitals use information about patients.
-
April 2, 2020Couple return to leave their own mark on campus where they met
A couple returned to Swansea University to leave their own legacy at the place where they first met more than 60 years ago.
-
April 1, 2020How your CoronaDiary could help us understand more about living through a pandemic
Has living with isolation and social distancing inspired you to put pen to paper? If so, you could be part of an unique social research project examining how society lives through coronavirus.
-
April 1, 2020Legal academic helps endorse guidance for home buyers in health crisis
A Swansea University academic has been working alongside The Law Society to endorse industry-wide guidance to conveyancing firms advising clients on house moves during the coronavirus crisis.
-
March 31, 2020South Wales industry consortium established to support the NHS covid 19 response
Teams from across Swansea University are coming together to support a newly established consortium – SWARM (The South Wales Additive and Rapid Manufacturing Consortium) in its mission to support NHS Wales’ covid-19 response.
-
March 30, 2020Health and Care Research Wales announce £4.5m investment in SAIL Databank
The new funding, which will maintain SAIL Databank for at least the next 5 years, comes as part of a £44 million investment package from Welsh Government into health and social care research to improve care and services.
-
March 27, 2020Students get set to support frontline NHS colleagues during virus crisis
Midwifery and paramedic students from Swansea University will be lending their support to frontline NHS colleagues in the fight to against the coronavirus pandemic.
-
March 27, 2020Swansea couple produce hand sanitiser amid Covid-19 pandemic
A Swansea University lecturer and her husband have transformed their popular business to produce approved hand sanitiser amid the ongoing coronavirus pandemic.
-
March 26, 2020Snake venom evolved for prey not protection
It is estimated that every year, over 100,000 human deaths can be attributed to snakebite from the world’s 700 venomous snake species – all inflicted in self-defence when the snakes feel threatened by encroaching humans. However, new research from a joint Bangor/Swansea team concludes that snake venom did not evolve as a defence mechanism.
-
March 26, 2020CADR secures funding boost to support ageing research in Wales
Swansea University’s Centre for Ageing and Dementia Research (CADR) has been awarded £2.8m in funding to extend their project for a further five years until 2025.
-
March 25, 2020Technocamps launch virtual resources to aid schools and pupils
Swansea University’s Technocamps project have launched a series of free online resources to support pupils, teachers and parents amid the Covid-19 outbreak.
-
March 24, 2020Staff give medical supplies and space to help NHS tackle coronavirus
Staff at Swansea University have rallied together to provide essential items to their local hospital to support them during the Covid-19 outbreak.
-
March 23, 2020Students step in to offer childcare to vital health workers
A group of Swansea University students have come up with a practical way of helping NHS staff during the coronavirus pandemic.
-
March 17, 2020Semiconductors can behave like metals and superconductors
The crystal structure at the surface of semiconductor materials can make them behave like metals and even like superconductors, a joint Swansea/Rostock research team has shown. The discovery potentially opens the door to advances like more energy-efficient electronic devices.
-
March 11, 2020Centenary appeal to former CELTA students
As part of Swansea University’s Centenary celebrations, its English Language Training Services has embarked on a global hunt to track down former students.
-
March 11, 2020Swansea University shortlisted for three prestigious nursing awards
Two outstanding Swansea University students are in the running for the Most Inspirational Student of the Year award in this year’s Student Nursing Times Awards.
-
March 10, 2020Swansea University playing key role in dementia research
Health records from over 80% of the Welsh population have been used to create the UK’s first national-scale health database for dementia research, which is housed at Swansea University.
-
March 10, 2020750,000 seeds planted in Wales in UK’s biggest seagrass restoration scheme
Sky Ocean Rescue, WWF and Swansea University have marked a major milestone in the biggest seagrass restoration project ever undertaken in the UK – planting over 750,000 seagrass seeds in Dale Bay in Pembrokeshire.
-
March 9, 2020University holds bike ride to celebrate International Women’s Day
Swansea University staff and students celebrated International Women’s Day with a group cycle ride from the University campuses to the Civic Centre.
-
March 6, 2020Major doctoral training boost for Swansea University
Swansea University has been awarded £2.9million for the EPSRC Doctoral Training Partnership 2020-21.
-
March 5, 2020Researchers detect Lamb shift in antihydrogen
Swansea University physicists, as leading members of the ALPHA collaboration at CERN, have reported the first measurement of fine structure in Antihydrogen that relates to Willis Lamb’s famous discovery almost 70 years ago.
-
March 3, 2020How best to integrate renewable energy sources into the electricity grid
A team from the University's Energy Safety Research Institute will be examining how best to integrate renewable energy sources into the UK power grid, helping to cut carbon emissions, thanks to a new £244,000 research award from the Engineering and Physical Sciences Research Council.
-
February 28, 2020Oriel Science returns to Waterfront Museum for Super Science Swansea
Swansea University’s Oriel Science will be returning to the National Waterfront Museum on Sunday, 8 March to host “Super Science Swansea” as part of British Science Week.
-
February 27, 2020Major award for project engaging young people with the world of books
DylanED, a Swansea University initiative aimed at introducing children and young people to the world of literature, will receive a major boost from the Rhys Davies Trust over the next three years.
-
February 26, 2020Swansea University expands free legal advice clinic, following surge in demand
Since launching in August 2017, the number of clients accessing free legal advice from students at Swansea University’s Law Clinic has more than doubled.
-
February 19, 2020Swansea student stars in Brain Tumour Awareness campaign
A Swansea University student, who was inspired to pursue a career in healthcare following the death of his father and grandad to brain tumours, is starring in a campaign to help find a cure for the disease.
-
February 14, 2020Student ambassadors appointed to promote Welsh language study at Swansea University
The Coleg Cymraeg Cenedlaethol has recruited four student ambassadors at Swansea University who will work to encourage more prospective students to study part of their degree courses through Welsh.
-
February 14, 2020Swansea to host Richard Burton Film Festival
Six films starring Richard Burton will be screened at Swansea’s Cinema & Co as part of a one-off festival celebrating the life of the Hollywood icon from Pontrhydyfen.
-
February 14, 2020Double success for University drug resistance research
Swansea University research into the threat posed by antifungal drug resistance has been highlighted in two prestigious international journals.
-
February 14, 2020Smarter, cleaner, greener steel
Climate change groups, companies and university researchers from across the UK have been exploring how they can contribute to a smart, green and clean steel industry, at an event organised by the Swansea-led SUSTAIN project.
-
February 14, 2020Major study shows climate change can cause abrupt impacts on dryland ecosystems
A Swansea University academic has contributed to a major study published in the journal Science, which shows the increases in aridity in some parts of the world may produce abrupt changes of ecosystems in areas where more than 2 billion people live.
-
February 13, 2020University’s new course gets set to revive city’s pharmacy training tradition
Plans for the launch of Swansea University’s new pharmacy degree programme are now well under way but it won’t be the first time future pharmacists have been trained in the city.
-
February 6, 2020Life science innovation project wins extra €5m investment
A unique Irish-Welsh partnership involving life science expertise at Swansea University has won €5 million of additional funding.
-
February 6, 2020First Minister launches research centre to develop future engineers in Wales
New engineering research institute set to deliver high impact, fundamental and applied research through academia-industry partnerships, marked by launch with First Minister.
-
February 6, 2020The world’s biggest iceberg is about to enter the open ocean
Scientists from Swansea University have revealed that A68, the world’s largest iceberg, is about to enter the open ocean for the first time.
-
February 6, 2020University wins funding for two projects to help public contribute to research
Swansea University has been awarded funding from the UK government for two projects, which will enable the public to contribute to research and innovation projects that affect their lives.
-
February 4, 2020Volunteers plant 50 oak trees to mark Swansea University’s centenary
As part of Swansea University’s 100th birthday celebrations, staff and student volunteers have planted 50 oak trees across the University’s Singleton and Bay campuses.
-
February 3, 2020Student nurse Laura shows her commitment to patient wellbeing
A Swansea University student has launched a campaign to collect basic toiletries and resources for hospital patients who are unable to access them themselves.
-
February 3, 2020New bushfire satellite images give early warning of long term effects
New data from Swansea University has showed that the bushfires raging in Australia are likely to pollute air quality over a very wide geographical area and could have a long term negative impact on public health.
-
January 31, 2020Awards celebrate research and innovation at Swansea University
From the screening of infectious diseases, to early diagnosis of bowel cancer, understanding the environmental impact of wildfires, responding to online terrorist propaganda, developing safety equipment for professional athletes and showcasing Science in the community; the astonishing range of research and innovation carried out at Swansea University was in the spotlight at the Research and Innovation Awards 2020.
-
January 30, 2020University in Top 100 LGBT Inclusive Employers
Swansea University has been named in the UK’s top 100 most inclusive employers for LGBT staff for the fifth year in a row.
-
January 30, 2020Swansea Soapbox Science 2020 appeals for speakers
Swansea University is appealing for female scientists and engineers to take part in this year’s Soapbox Science by hitting the streets of Swansea to share their passion and inspire the next generation of scientists.
-
January 27, 2020University joins quest to discover why some patients stay cancer-free
Eminent philanthropist and three-time cancer survivor James Hull has joined forces with six universities across the country to investigate why cancer returns in some people and not others.
-
January 24, 2020Swansea University awarded Erasmus funding to support Texas student exchanges
Swansea University has been awarded €131,400 (£112,588) funding to support student mobility between Swansea and the University of Houston.
-
January 24, 2020International and under-represented voices dominate the longlist for the 15th anniversary of the Swansea University Dylan Thomas Prize
This year's Swansea University Dylan Thomas Prize longlist combines a rich, international collection of young, experimental writers who are offering platforms for under-represented voices and exploring pressing social and world themes across identity, culture and power.
-
January 23, 2020Swansea zoologist wins prestigious Humboldt Research Award
Rory Wilson, a distinguished professor of zoology at Swansea University, has been granted a Humboldt Research Award by the Alexander von Humboldt Foundation of Germany.
-
January 22, 2020From touchscreens to 5G: carbon nanotube production gets green light
A new method of producing carbon nanotubes - tiny molecules with incredible physical properties used in touchscreen displays (pictured), 5G networks and flexible electronics – has been given the green light by researchers, meaning work in this crucial field can continue.
-
January 17, 2020Swansea University Dylan Thomas Prize heads to Jaipur Literature Festival to announce its 2020 longlist live in celebration of its 15th year
To celebrate 15 years of the Swansea University Dylan Thomas Prize, the Prize is announcing this year's longlist live from the Jaipur Literature Festival.
-
January 14, 2020Cancer diagnosis centre cuts waits from 84 days to 6
A rapid diagnosis centre has cut waiting times for patients with non-specific symptoms who may have cancer from 84 days to 6, and it costs less than current usual care if used at more than 80% of capacity, a new study by Swansea University researchers and NHS colleagues has shown.
-
January 14, 2020Multi-million pound funding secured for City Deal
A multi-million pound early new year present has arrived to turbo-charge the Swansea Bay City Deal.
-
January 14, 2020University-designed programme increases children’s knowledge of their carbon footprint
An interdisciplinary team at Swansea and Bangor universities have designed a programme which encourages school-aged children to think about their personal impact on climate change.
-
January 14, 2020Internet use reduces study skills in university students
Research conducted at Swansea University and the University of Milan has shown that students who use digital technology excessively are less motivated to engage with their studies, and are more anxious about tests. This effect was made worse by the increased feelings of loneliness that use of digital technology produced.
-
January 10, 2020Student entrepreneurs win support from successful alumni in new mentorship programme
Successful formers students have returned to Swansea University to help encourage the next generation of young entrepreneurs.
-
January 9, 2020International experts call for unified approach to addressing loneliness in letter to The Lancet
International experts, including researchers from Swansea University, have published a letter in The Lancet medical journal calling for a unified approach to addressing the global challenge of loneliness.
-
January 6, 2020University pays tribute to Taliesin pioneer Sybil Crouch
It is with great sadness that we heard Sybil Crouch, formerly the Head of Cultural Services and leader of Taliesin Arts Centre at Swansea University, has died.
-
January 3, 2020New research shows domestic animals link virus spread among humans and wildlife
Our domesticated animals - both pets and livestock – hold the key to the spread of viruses among humans and wildlife according to new research involving Swansea University.